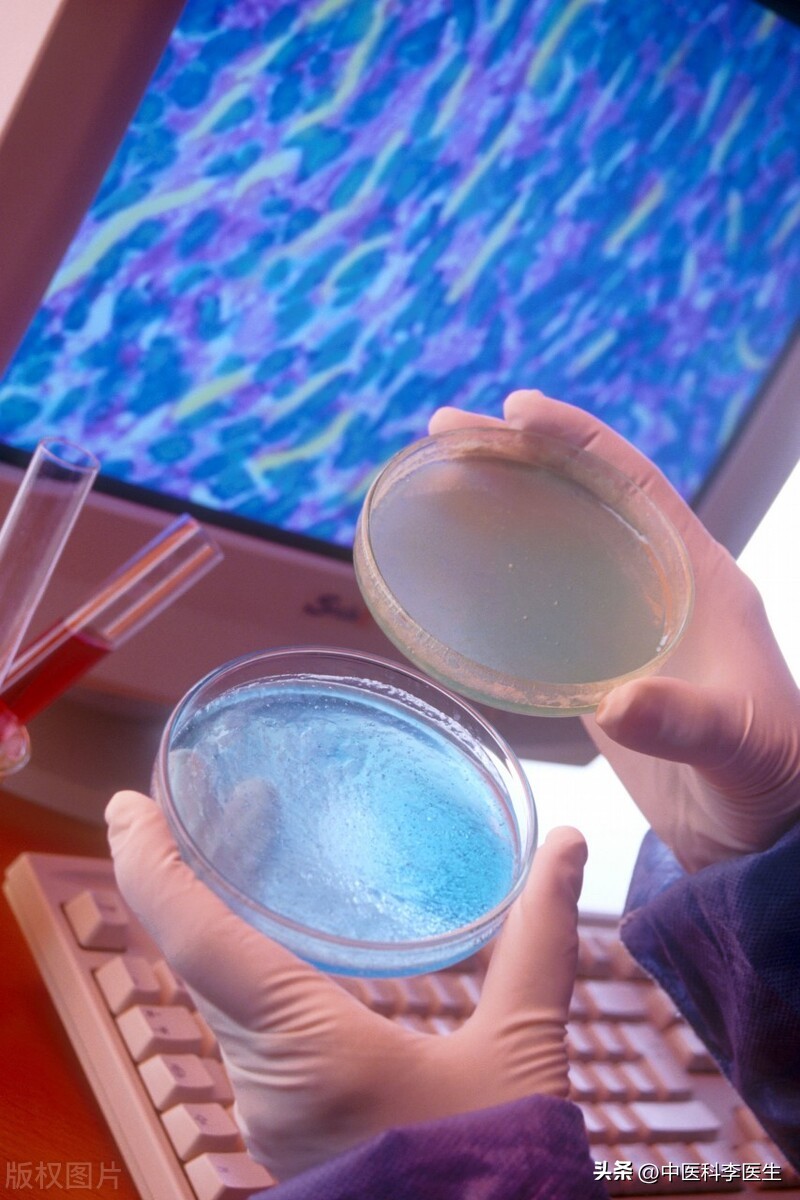
早期17种癌症治愈率排名,早期癌症治愈率最大可达95%以上

癌症是从癌细胞发展而成的,又叫恶性肿瘤;
癌细胞是从正常细胞变异后产生的,不听人体控制;
正常细胞怎么会发生变异?主要是DNA控制的细胞分裂、复制出错,或DNA自身变异。

人体细胞的更替和新陈代谢是一样的,从不停歇,正常情况下,细胞分裂复制是一变二、二变四的过程,但不排除一些意外情况。细胞分裂时出错,癌细胞就出现了。
如果人体免疫细胞未能及时清除,癌细胞就会扎根,慢慢长大成为隐患。由于人的年龄越大,细胞分裂的次数越多,所以,理论上年龄越长,人患癌的可能也越大。
不过,除了年龄,有5个因素也是癌症的重要诱因,分别是:
1、有肿瘤家族史。
2、发生与肿瘤相关的基因突变情况。
3、有患癌的高危因素,如抽烟、喝酒、长期炎症等。

4、有环境暴露史,如放射物质接触、石棉影响等。
5、饮食不洁,长期生活在污染环境或过量添加剂环境。
不少人认为,癌症是可怕的“不治之症”,特别是经常听到诸如肺癌、肝癌、胃癌、胰腺癌等致命的消息,加深了恐惧。

实际上科学家与癌症的斗争一直未进步,有的癌种经过药物和治疗手段更新,或早期发现早做治疗,已获得很高的生存率,与一些肿瘤只有30%—50%的5年生存率相比,它们已达90%以上,是了不起的进步,给患者带来战胜的动力和希望。
总的看,有6种癌症治愈率已达90%以上,分别有:

1、前列腺癌——癌症中的异类,如果说大部分癌细胞是失控生长,狂飙突进的,前列腺癌细胞属于“蜗牛型”的,一不乐意还会停止生长一段时间,所以,即使发现已经很晚了,也能被治愈,但如果其发生远端转移,会比较难办,不过总体5年生存率约99%。
前列腺癌,要通过直肠指检或PSA血液检测筛查,如男士有小便困难、尿血问题,要高度重视。

2、甲状腺癌——癌症中的钉子户,很多癌症是通过“开枝散叶”证明自身强大和威胁身体的,甲状腺癌则属于“特别恋家”的类型,不喜欢挪窝,所以即使肿瘤很大,手术切除就能解决大部分问题,但切除后患者要服用替代甲状腺分泌激素的药物,总体5年生存率达98%以上。
甲状腺癌的筛查没有很好的方式,如果颈部有肿块或已吞咽困难,就要及时检查。

3、黑色素瘤——发生比较隐蔽,但早期时只要患者足够警惕,会一眼就辨认出来,特别是其处于发展阶段,未转移到皮肤以外的部位,可以选择手术切除即可,5年生存率达92%以上。
定期体检,可以及时发现有无黑色素瘤,特别注意检查头皮、背部、大腿根部及脚趾之间,有黑色素瘤家族史的不要大意。

4、早期乳腺癌——主要是0期和1期的乳腺癌,医生有足够的信心和技术去对付它们,以女士为主的群体,对乳腺的重视也日渐提高,为及时治疗创造了条件,药物或手术治疗,总体生存率接近100%。
只要发现得早,乳腺癌的威胁可降到最低水平,平时筛查可选择钼靶、乳腺X线检查,女士建议从45岁开始。
5、急性早幼粒白血病——血癌的一种类型,儿童和成年人多见,早期症状凶险,如果错过治疗时机,患者凝血会出现问题,特别是出现脑内出血及其它并发症,比较危险。

这种凶险的血癌,被我国工程院院士王振义和中医师张亭栋,分别用不同的方式提高了治愈效果,且两种方式可以互补,治愈率总体超过90%。

王振义院士是通过“全反式维甲酸”,去让癌细胞“改过自新”,效果突出。而张亭栋则是从中药方中采用“砷制剂治疗”,“以毒攻毒”获得较好的疗效。
所以,这5种癌症目前均有较好的治愈率,不幸患上这些癌症的人,是不幸中的万幸,通过坚持治疗,能获得较高的生存率,达到临床治愈。
任何癌症,早发现、早介入、早治疗,是一个十分有效的方法,注意定期筛查,不走过场,对身体健康是一种负责任的态度。